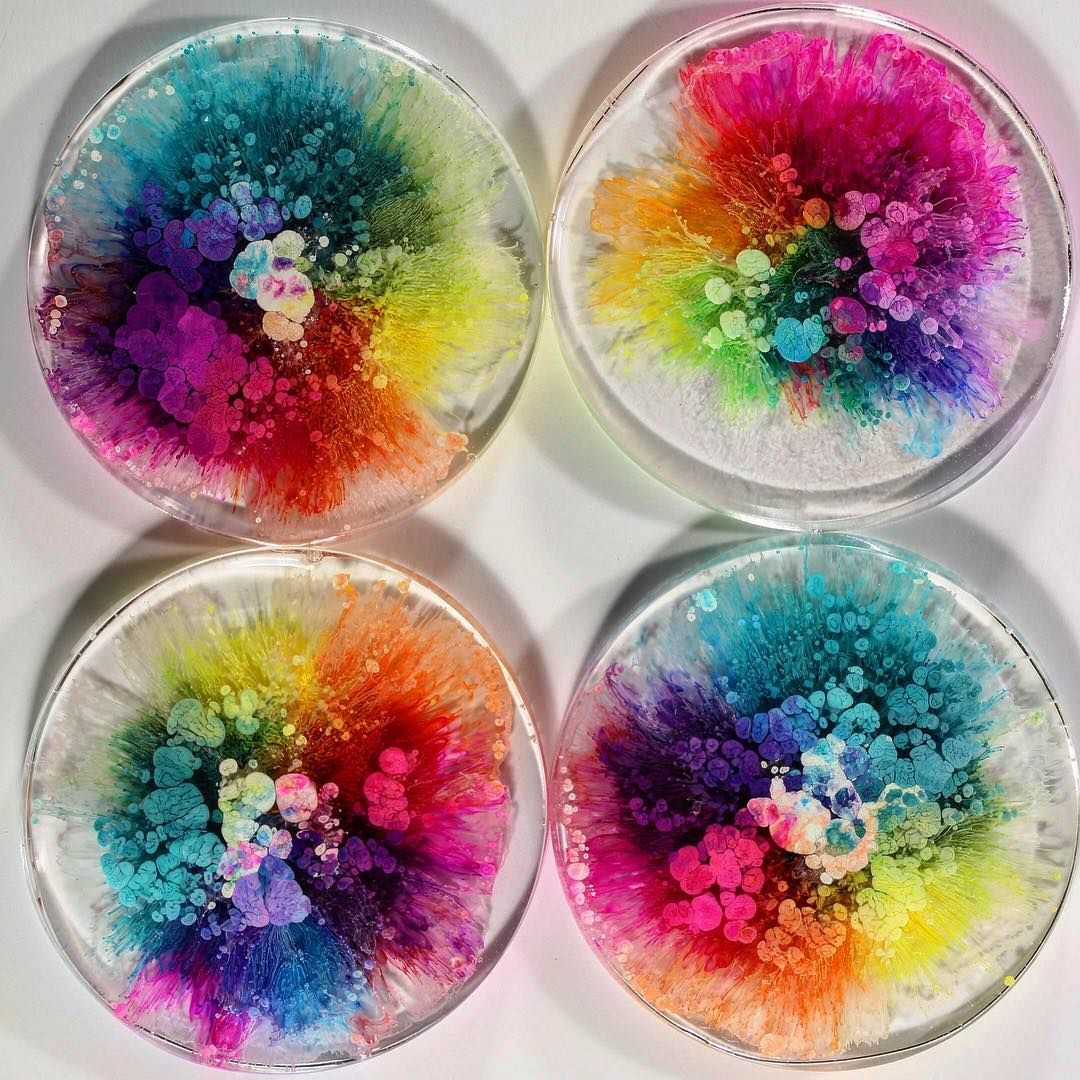

Мастер-классы и занятия
для детей и взрослых
+79636873575
Мастер-классы и занятия
для детей и взрослых
Работаем со сказочными сюжетами и волшебными материалами. Развиваем фантазию, творческие способности и моторику.
Зефирная глина
Мастер-класс для детей и взрослых. Волшебство зефирной глины. Готовое изделие сразу. 5+
Петри Арт
Мастер-класс с превращениями материалов. Для детей и взрослых. Готовое изделие сразу. 6+
Песочные фантазии
Учимся создавать рисунки и сюжеты из песка в световой песочнице. Для самых маленьких 3+
Рисуем на воде
Осваиваем волшебную технику Эбру - рисование на воде. Готовый рисунок сразу 3+
Пробуем импрессионизм
Изучаем искусство импрессионизма и пробуем сами сделать работу в этой технике. 5+
Таруса, Пролетарская 16
парковки нет
Если вы не можете прийти пешком, вам нужно подъехать, высадить пассажиров и запарковать автомобиль на соседней улице.
Парковка в Тарусе везде бесплатная
парковки нет
Если вы не можете прийти пешком, вам нужно подъехать, высадить пассажиров и запарковать автомобиль на соседней улице.
Парковка в Тарусе везде бесплатная